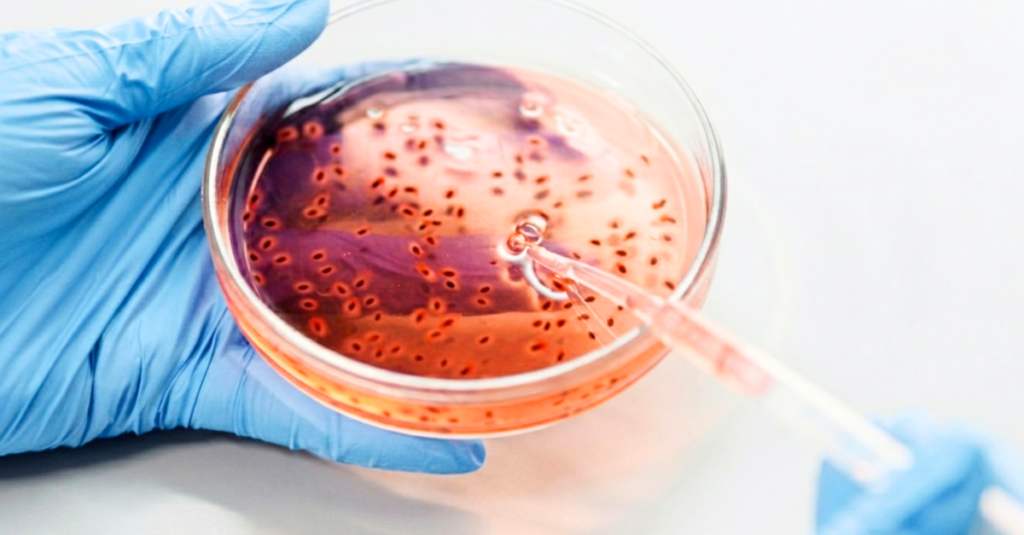

Escrito por:
Jordi Gibert, responsable de la Unidad de Biotecnología de Klinea Biotech and Pharma engineering
Albert Canet, ingeniero de proyectos de Klinea Biotech and Pharma engineering
Francisco Valero, coordinador del grupo de ingeniería de bioprocesos y biocatálisis aplicada
Modificar genéticamente una célula para que produzca un producto biotecnológico ajeno a su propia naturaleza, produciéndolo de forma más eficiente en comparación con organismos nativos que lo producen de forma natural, o bien para que la célula produzca un producto biotecnológico modificado respecto a su estructura original: es una herramienta habitual que se utiliza para la producción de la inmensa mayoría de biofármacos, por no decir “casi” todos, gracias a la tecnología del DNA recombinante, desarrollada en los años 70 del siglo pasado.
De esta manera se ha conseguido que en la actualidad se dispongan comercialmente de anticuerpos monoclonales, vacunas de última generación, factores sanguíneos, factores de crecimiento, hormonas y otras enzimas y proteínas recombinantes de uso terapéutico.
El uso de estos biofármacos se ha generalizado, llegando a un valor de mercado estimado en 617 billones americanos de dólares en 2024, lo cual representa ya una parte importante de los 1747 billones americanos de dólares de valor de mercado total de fármacos en 2024, y con una perspectiva de que su mercado se doble en 2032 [1,2].

Tabla 1. Ejemplos de los principales productos biofarmacéuticos por volumen de ventas en 2015; para más información de productos biofarmacéuticos ver referencias [6,7,8]
Uno de los primeros de estos biofármacos de uso comercial fue la insulina producida mediante la bacteria escherichia coli, aprobada por la FDA en 1982 [3]. Este primer paso demostró que el uso de microorganismos – como bacterias, principalmente E.coli, y levaduras, como Sacchareomyces cerevisiae y Pichia pastoris – se podria extender a la producción de una amplia gama de biofármacos [4].
En general las plataformas microbianas tienen velocidades de crecimiento superiores a las células de mamíferos y pueden llegar a densidades celulares superiores [4], llegando a productividades mayores; estas ventajas convierten a las plataformas microbianas en factorías celulares eficientes a nivel de costes en comparación a las plataformas de células de mamífero en la producción de biofármacos – y en general en la producción de compuestos recombinantes de uso en otros sectores más allá del farmacéutico –. Sin embargo, la falta o poca capacidad de bacterias y levaduras de realizar modificaciones postraduccionales de los bioproductos idénticas a la de los organismos superiores ha limitado su uso en la producción de varios biofármacos, siendo las células de mamífero las más utilizadas para este tipo de bioproductos; estas modificaciones – también conocidas como “humanizaciones”, como por ejemplo la correcta secuencia de glicosilación – son necesarias para el correcto funcionamiento de algunas moléculas y/o su rechazo por parte del sistema inmunitario.
La tendencia en los últimos años es que las plataformas de células de mamíferos han ganado terreno a la microbianas en la producción de biofármacos – especialmente por la irrupción y auge de los anticuerpos monoclonales, los cuáles requieren modificaciones postraduccionales – [5]. Así lo demuestran los números de aprobaciones de biofármacos: hasta 1989 las plataformas de células de mamífero representaban el 33% del total, mientras que en el período de 2015-2018 fueron el 79% [5]. En volumen de mercado ya en 2015 solo 4 del top 10 de biofármacos eran producidos por plataformas microbianas, tal como indica la tabla 1 [3]. No obstante, donde el uso de microorganismos tiene aún un papel destacado es en la producción de proteínas, factores sanguíneos, hormonas, factores de crecimiento, interferones, interleucinas, factores tumorales y vacunas [5]. Además, hay que mencionar que el uso de plásmidos para distintas terapias – como las terapias génicas – impulsa también el uso de plataformas microbianas, ya que son producidos con microrganismos.

Figura 1. Análisis de muestras biológicas en laboratorio
Actualmente hay varios grupos de investigación desarrollando factorías celulares basadas en plataformas microbianas – mediante modificaciones genéticas – con capacidad y/o mejora en las modificaciones postraduccionales que pueden incorporar el patrón de glicosilación característico de las células de mamífero, así como también mejoras en otros problemas no menos importantes como son la secreción y plegamiento de las moléculas sintetizadas [5,6]; por ejemplo, E. coli es comúnmente conocida por tener el plegamiento deficiente de las moléculas sintetizadas, por lo que se acumulan en su interior en forma insoluble, lo que se conoce como cuerpos de inclusión – esto requiere un proceso adicional de procesamiento de estos cuerpos insolubles para obtener de forma activa el producto recombinante final–. En el caso de la levadura P. pastoris hay cepas comerciales modificadas con el mismo patrón de glicosilación que los humanos, como la plataforma Pichia GlycoSwith ®.
En la parte operativa industrial e ingeniería, las dos plataformas – i.e. células de mamífero y microorganismos – presentan la misma estructura de bioproceso: primero crecimiento celular, asociado a la producción de la molécula – conocido como upstream –, y la posterior recuperación y purificación de la molécula – conocida como downstream –. No obstante, las plataformas microbianas presentan tiempos de producción más cortos y sistemas de altas densidades celulares, haciendo que los procesos sean más económicos, comparados con las células de mamífero, como se ha comentado anteriormente – a esto se le suma que los medios de cultivo de las células de mamífero suelen ser mucho más caros que los de bacterias y levaduras –.
En lo referente a las operaciones, seguramente en el downstream es donde hay más diferencias entre las dos plataformas: en las producciones con microorganismos en algunos casos hay etapas de solubilización y plegamiento de proteínas, como el caso de E. coli comentado anteriormente, mientras que en las células de mamíferos a menudo se necesitan de etapas de inactivación vírica. No obstante, por la general la producción con CHO – la principal plataforma de células mamíferas para la producción de biofármacos – presenta un downstream más simple y/o eficiente que las plataformas microbianas, ya que la síntesis y expresión de las biomoléculas es más pura [5].
Por otro lado, si se analizan las características de ingeniería de los equipos utilizados, en general sus atributos son similares – i.e. agitación, aporte de oxígeno, control temperatura, entre otros –, aunque con distintos rangos de valores. Un buen ejemplo de ello es la irrupción de las tecnologías single use, especialmente en los biorreactores; los biorreactores single use son de gran utilidad para las plataformas de células de mamífero – de hecho, actualmente la inmensa mayoría de biorreactores utilizados en células de mamífero son de single use –, evitando principalmente contaminaciones, pero suelen tener una baja transferencia de materia – admiten poca agitación – y una baja transferencia de calor – son materiales con mala conducción térmica – que limitan su uso en las plataformas microbianas. Sin embargo, ya existen biorreactores single use mejorados aplicándose a la producción en factorías celulares de bacterias y levaduras.
Aunque las plataformas microbianas presentan limitaciones biológicas quedando fuera de poder producir ciertos biofármacos, a nivel técnico sus productividades superan a las plataformas de células de mamíferos. La investigación científica en la producción de biofármacos con microorganismos tiene como objetivo solventar estas limitaciones biológicas.
Si estás interesado/a en conocer más sobre instalaciones para la producción de biofármacos y cómo podemos ayudarte, contáctanos: klinea@kliena.eu.
Bibliografía
1. Biopharmaceuticals Market Size, Share & Industry, By Type, By Application, By Distribution Channel and Regional Forecast 2025-2032; Fortune Business Insights; 2025
2. Pharmaceutical Drugs Global Market Report 2025; The Business Research Company; 2026
3. Biopharmaceuticals from microorganism: from production to purification: Angela Faustino Jozala et al.; Brazilian Journal of Microbiology; 2016
4. Whitepaper: Advancements in microbial manufacturing of biopharmaceuticals; Boehringer Ingelheim; 2024
5. Microbial protein cell factories fight back?; Lukas A. Rettenbacher; Trends in Biotechnology; 2022
6. Production of Biopharmaceuticals in E. coli: Current Scenario and Future Perspectives; Mohammed N. Baeshen et al.; Journal and Microbiology and Biotechnology; 2015
7. Yeast as Biopharmaceutical Production Platforms; Natalja Kulagina et al.; Frontiers in Fungal Biology; 2021
8. Evolving Paradigms of Recombinant Protein Production in Pharmaceutical Industry: A Rigorous Review; Achuth Jayakrishnan et al.; Sci; 2024